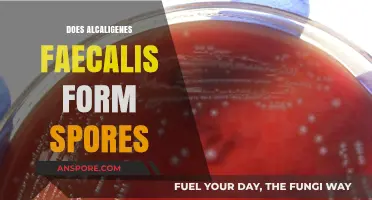
Alcaligenes Faecalis: Understanding Its Sporulation Capabilities and Implications

Algae, a diverse group of photosynthetic organisms, exhibit a wide range of reproductive strategies, and the question of whether they produce spores is a fascinating aspect of their biology. While not all algae form spores, many species do, particularly those in the groups of green algae, red algae, and brown algae. These spores serve as a means of dispersal and survival, allowing algae to colonize new environments and endure harsh conditions. For instance, certain algae release motile spores, known as zoospores, which can swim to find suitable habitats, while others produce non-motile spores that are carried by wind or water currents. Understanding the presence and function of spores in algae is crucial for comprehending their life cycles, ecological roles, and potential applications in biotechnology and environmental science.
| Characteristics | Values |
|---|---|
| Does Algae Have Spores? | Yes, some algae produce spores as part of their life cycle. |
| Types of Spores | Zygospores, aplanospores, akinetes, zoospores, and autospores, depending on the species. |
| Function of Spores | Spores serve as a means of reproduction, dispersal, and survival in adverse conditions. |
| Life Cycle Stage | Spores are typically produced during the asexual or sexual reproductive phases of algae. |
| Examples of Algae with Spores | Zygnematophyceae (zygotes form zygospores), Chlorophyceae (produce zoospores), and Cyanobacteria (form akinetes). |
| Sporulation Conditions | Spores are often produced in response to environmental stressors like nutrient depletion, desiccation, or temperature changes. |
| Mobility of Spores | Zoospores are motile (move using flagella), while other spores (e.g., aplanospores) are non-motile. |
| Role in Ecosystem | Algal spores contribute to species dispersal, colonization of new habitats, and genetic diversity. |
| Comparison to Fungi | Unlike fungal spores, algal spores are often larger and less numerous but serve similar ecological functions. |
| Research Significance | Understanding algal sporulation is crucial for studying algal biology, ecology, and potential biotechnological applications. |
Explore related products
What You'll Learn
- Algae Reproduction Methods: Algae reproduce via spores, fragmentation, or sexual/asexual means depending on species
- Types of Algae Spores: Zoospores, aplanospores, and akinetes are common spore types in algae
- Spore Formation Process: Spores develop in sporangia through mitosis or meiosis in algae life cycles
- Role of Spores in Survival: Spores help algae survive harsh conditions like drought or extreme temperatures
- Comparison to Plant Spores: Algae spores differ from plant spores in structure, function, and dispersal mechanisms

Algae Reproduction Methods: Algae reproduce via spores, fragmentation, or sexual/asexual means depending on species
Algae, a diverse group of photosynthetic organisms, employ a variety of reproductive strategies to ensure their survival and proliferation. One of the most intriguing methods is spore production, a feature not exclusive to plants but also found in certain algal species. These spores, akin to tiny survival pods, are lightweight and easily dispersed, allowing algae to colonize new environments efficiently. For instance, species like *Ulva* (sea lettuce) release spores that can travel vast distances on ocean currents, ensuring genetic diversity and adaptability.
Fragmentation is another ingenious reproductive tactic used by some algae. This process involves the breaking off of small pieces from the parent organism, which then grow into new individuals. Imagine a filamentous alga like *Spirogyra*—when a fragment detaches, it can develop into a fully functional alga, essentially cloning the parent. This method is particularly effective in stable environments where the conditions for growth are consistent, as it requires no energy-intensive processes like spore production.
Sexual and asexual reproduction further highlight the versatility of algal reproductive strategies. In sexual reproduction, algae produce gametes that fuse to form a zygote, which can develop into a new organism. This method promotes genetic recombination, enhancing adaptability to changing environments. Asexual reproduction, on the other hand, involves the division of a single cell or organism into two or more daughter cells, a process known as binary fission. This rapid and energy-efficient method is common in species like *Chlamydomonas*, where a single cell can quickly multiply under favorable conditions.
Understanding these reproductive methods is crucial for both ecological and practical applications. For example, in aquaculture, controlling algal blooms often requires knowledge of their reproductive cycles. By identifying whether an alga reproduces via spores, fragmentation, or other means, scientists can develop targeted strategies to manage or cultivate these organisms effectively. Additionally, the study of algal reproduction provides insights into evolutionary biology, as these methods reflect adaptations to diverse environments, from freshwater ponds to the open ocean.
In practical terms, hobbyists and professionals alike can benefit from this knowledge. For instance, in maintaining a balanced aquarium ecosystem, recognizing whether an alga reproduces asexually can help in preventing overgrowth. Similarly, in algal biotechnology, understanding spore production can optimize the cultivation of species used in biofuel production or as food supplements. By leveraging these reproductive methods, we can harness the potential of algae more effectively, whether for environmental management or industrial applications.
Is Spore Available for Xbox 360? Compatibility and Alternatives Explained
You may want to see also

Types of Algae Spores: Zoospores, aplanospores, and akinetes are common spore types in algae
Algae, often overlooked in the grand scheme of plant biology, produce a fascinating array of spores as part of their life cycles. Among these, zoospores, aplanospores, and akinetes stand out for their unique adaptations and roles. Zoospores, for instance, are motile spores equipped with flagella, allowing them to swim through water in search of favorable conditions for growth. This mobility is a critical survival mechanism, particularly in aquatic environments where resources can be patchy and unpredictable. Understanding these spore types not only sheds light on algal biology but also has practical implications, such as managing algal blooms in water bodies or cultivating algae for biotechnological applications.
Consider the lifecycle of zoospores, which are often produced by algae like *Chlamydomonas* and *Ulva*. These spores are short-lived but highly efficient, capable of detecting chemical cues in their environment to guide their movement. For example, zoospores of the green alga *Ulva* (sea lettuce) can sense the presence of specific organic compounds on surfaces, ensuring they settle in nutrient-rich areas. In contrast, aplanospores are non-motile spores that form under adverse conditions, such as nutrient scarcity or extreme temperatures. Unlike zoospores, aplanospores rely on external factors like water currents or animals to disperse them. This passive dispersal strategy highlights the diversity of survival tactics among algal spores.
Akinetes represent another intriguing spore type, primarily found in cyanobacteria and some green algae. These thick-walled, dormant spores are produced in response to environmental stress, such as desiccation or cold. Akinetes can remain viable for extended periods, sometimes years, until conditions improve. For instance, *Anabaena*, a filamentous cyanobacterium, forms akinetes that can withstand harsh winters in freshwater lakes, ensuring the species' survival. This ability to enter a dormant state is particularly valuable in unpredictable environments, making akinetes a key player in algal resilience.
From a practical standpoint, understanding these spore types can inform strategies for controlling algal blooms, which often disrupt aquatic ecosystems and water supplies. Zoospores, with their motility, can rapidly colonize new areas, making early detection and intervention crucial. Aplanospores, though less mobile, can accumulate in sediments and re-emerge under favorable conditions, necessitating long-term monitoring. Akinetes, with their dormancy, pose a challenge for eradication, as they can persist even after environmental conditions have been restored. By targeting the specific mechanisms of each spore type, such as disrupting zoospore motility or inducing akinete germination prematurely, more effective management techniques can be developed.
In conclusion, the diversity of algal spores—zoospores, aplanospores, and akinetes—reflects the adaptability of algae to varied and often challenging environments. Each spore type has evolved distinct strategies for survival, dispersal, and dormancy, contributing to the success of algae across ecosystems. Whether you're a researcher, environmental manager, or simply curious about the natural world, appreciating these differences offers valuable insights into the intricate lives of algae and their impact on our planet.
Pollen Grains vs. Spores: Understanding the Key Differences and Similarities
You may want to see also

Spore Formation Process: Spores develop in sporangia through mitosis or meiosis in algae life cycles
Algae, often overlooked in discussions of spore-producing organisms, indeed engage in spore formation as a critical part of their life cycles. This process occurs within specialized structures called sporangia, where spores develop through either mitosis or meiosis, depending on the algal species and life cycle stage. Understanding this mechanism sheds light on algae’s adaptability and survival strategies in diverse environments.
The spore formation process begins with the differentiation of sporangia, which serve as protective chambers for spore development. In species like *Chlamydomonas*, a model green alga, sporangia form under stress conditions such as nutrient depletion or desiccation. Within these structures, cells undergo mitosis to produce asexual spores, ensuring rapid proliferation when conditions improve. Conversely, in more complex life cycles, such as those of brown algae (Phaeophyceae), meiosis occurs within sporangia to generate sexual spores (zoospores or gametes), promoting genetic diversity and long-term survival.
A key distinction lies in the type of spores produced. Asexual spores, formed via mitosis, are genetically identical to the parent cell and serve as a means of vegetative reproduction. These spores are common in unicellular and simple multicellular algae, enabling quick colonization of favorable habitats. Sexual spores, on the other hand, result from meiosis and are crucial for genetic recombination. For instance, in the life cycle of *Fucus*, a brown alga, meiosis in sporangia produces gametes that fuse to form a zygote, which develops into a new generation.
Practical observations of this process can be made in laboratory settings or natural habitats. For educators or researchers, culturing algae like *Volvox* or *Ulva* under controlled conditions allows for the visualization of sporangia and spore release. Microscopic examination reveals the intricate cellular divisions within sporangia, offering insights into the timing and triggers of spore formation. Field studies, particularly in intertidal zones, demonstrate how environmental cues such as light, salinity, and temperature influence sporangium development and spore dispersal.
In conclusion, the spore formation process in algae is a fascinating interplay of cellular division, environmental adaptation, and reproductive strategy. Whether through mitosis or meiosis, spores produced in sporangia ensure the resilience and diversity of algal populations. This knowledge not only enriches our understanding of algal biology but also highlights the broader significance of spores in the survival and evolution of photosynthetic organisms.
Can Psilocybin Spores Survive Digestion? Exploring the Science Behind It
You may want to see also
Explore related products

Role of Spores in Survival: Spores help algae survive harsh conditions like drought or extreme temperatures
Algae, often overlooked in discussions of survival strategies, employ a remarkable mechanism to endure extreme environmental challenges: spores. These microscopic structures are not merely reproductive units but lifeboats designed to weather harsh conditions such as drought, freezing temperatures, and desiccation. When water becomes scarce or temperatures plummet, certain algal species respond by producing spores that enter a dormant state, halting metabolic activity until conditions improve. This adaptive strategy ensures the continuity of algal populations in environments where survival would otherwise be impossible.
Consider the desert-dwelling cyanobacterium *Chroococcidiopsis*, which thrives in arid conditions by forming spore-like structures called akinetes. These akinetes can remain viable for decades, withstanding temperatures as high as 60°C and as low as -20°C. When rain finally arrives, the akinetes germinate, restoring the algal population within hours. Similarly, snow algae like *Chlamydomonas nivalis* produce thick-walled zygotes that survive freezing temperatures and intense UV radiation in polar regions. These examples illustrate how spores act as a biological insurance policy, allowing algae to persist in habitats that would otherwise be inhospitable.
From a practical standpoint, understanding spore formation in algae has significant implications for biotechnology and agriculture. For instance, drought-resistant algal spores could be engineered to enhance crop resilience in water-scarce regions. Researchers are already exploring the use of algal spores as bioindicators for environmental monitoring, as their presence or absence can signal changes in climate or water quality. To harness this potential, scientists recommend studying spore germination triggers, such as specific humidity levels or nutrient availability, to optimize their application in real-world scenarios.
Comparatively, algal spores share similarities with bacterial endospores and fungal spores, yet they are uniquely adapted to aquatic and semi-aquatic environments. Unlike bacterial endospores, which are nearly indestructible, algal spores retain a degree of vulnerability, requiring specific cues to reactivate. This balance between resilience and responsiveness highlights the elegance of algal survival strategies. By studying these mechanisms, we gain insights into how life persists in Earth’s most extreme habitats and how such adaptations might be leveraged for human benefit.
In conclusion, spores are not just a survival tool for algae but a testament to the ingenuity of life in the face of adversity. Their ability to endure drought, extreme temperatures, and other stressors underscores the importance of understanding these microscopic structures. Whether for scientific research, environmental conservation, or technological innovation, the role of spores in algal survival offers a wealth of untapped potential. By focusing on these adaptations, we can unlock new solutions to some of the most pressing challenges of our time.
Are Moss Spores Dangerous? Uncovering the Truth About Moss Exposure
You may want to see also

Comparison to Plant Spores: Algae spores differ from plant spores in structure, function, and dispersal mechanisms
Algae and plants both produce spores, but their structures reveal distinct evolutionary adaptations. Plant spores, such as those from ferns or mosses, are typically encased in a protective wall made of sporopollenin, a durable biopolymer that shields them from environmental stressors. Algae spores, in contrast, often lack this robust outer layer. For instance, many algal species produce zoospores, which are motile and surrounded by a thin, flexible cell membrane. This structural difference reflects their immediate need for mobility rather than long-term survival in harsh conditions. While plant spores are built to endure, algal spores prioritize rapid dispersal and immediate colonization.
Functionally, plant spores serve primarily as a means of asexual reproduction and long-distance dispersal, often remaining dormant until conditions are favorable for germination. Algae spores, however, are more versatile. Zoospores, for example, not only reproduce but also act as a survival mechanism during nutrient scarcity or environmental stress. Some algae, like *Chlamydomonas*, release spores that can switch between motile and dormant states depending on resource availability. This dual functionality highlights how algal spores are adapted for both immediate survival and propagation, whereas plant spores are more specialized for dispersal and delayed growth.
Dispersal mechanisms further underscore the differences between algal and plant spores. Plants rely on external agents like wind, water, or animals to carry their spores over long distances. Algae, particularly aquatic species, often employ self-propelled methods. Zoospores, equipped with flagella, swim actively to reach new habitats, ensuring rapid colonization of nutrient-rich areas. Terrestrial algae, such as those in the genus *Trentepohlia*, may rely on wind or rain splash, but their spores are still lighter and less protected compared to plant spores. This reliance on active or passive dispersal reflects the ecological niches each group occupies.
Practical applications of these differences are evident in biotechnology and ecology. Algal spores’ motility and rapid reproduction make them ideal for studying cellular processes and developing biofuels. For instance, *Chlorella* spores are cultivated for their high lipid content, which can be converted into biodiesel. Plant spores, with their durability, are used in seed banking and restoration projects. Understanding these distinctions allows researchers to harness the unique properties of each spore type effectively. Whether in a lab or the field, recognizing how algal and plant spores differ is key to leveraging their potential.
In summary, while both algae and plants utilize spores for reproduction and dispersal, their approaches diverge significantly. Algal spores prioritize mobility and immediate function, often at the expense of long-term durability. Plant spores, on the other hand, are built to withstand harsh conditions and travel far before germinating. These differences are not just evolutionary curiosities but practical considerations for anyone working with these organisms. By appreciating these distinctions, we can better understand and utilize the unique capabilities of algal and plant spores in science and industry.
Can Mold Spores Thrive Without Water? Uncovering the Truth
You may want to see also
Frequently asked questions
Yes, some types of algae, particularly those in the group of green algae (e.g., Zygnematophyceae and Chlorophyta), produce spores as part of their life cycle.
Algae spores are often referred to as zoospores, aplanospores, or akinetes, depending on their structure, mobility, and function in the algal life cycle.
No, not all algae produce spores. Some algae, like diatoms and dinoflagellates, reproduce primarily through cell division or other methods rather than spore formation.
Algae spores, such as zoospores, are often flagellated and motile, allowing them to swim to new habitats. Plant spores, in contrast, are typically non-motile and rely on wind or water for dispersal.